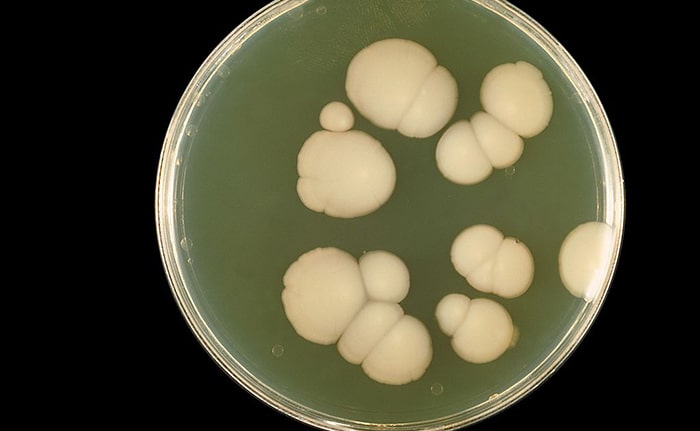

クラミジア おり もの 色 画像 (281 無料画像)
性病 性病科 とは?種類、症状、検査、治療など新宿駅前クリニック泌尿器科。
おりもののサインと受診が必要なタイミングについて〜 - いだてんクリニック。
女性がクラミジアに感染したとき出現する症状や知っておきたい予防策とは。
私のおりものの色やにおいって大丈夫?こんなおりものには要注意!女性ホルモン大学。
楽天市場 ふじメディカル 性病検査キット 女性用クラミジア の 性病検査 性感染症自宅で出来る性病検査 性病検査 自宅 性病 検査キットSTI検査 送料無料 早期発見 即日 匿名 STD 簡単 説明書 郵送 女 夏 セルフ 診断 おりもの検査 : ふじメディカル 楽天市場店。
クラミジア感染症になる原因・症状となったときの対処法を解説! - ルナレディースクリニックのメディア。
妊活中の女性必見!伸びるおりものの正体と妊娠しやすいタイミングを知ろう - 妊活・妊娠・安産の情報サイト - 子授かりネットワーク。
おりもの」について改めて考える『My Body, My Self. -カラダの疑問展-』で気づいたこと フェムテック調査団お試し-フェムテック調査団SPUR。
おりものが黄色・茶色・黄緑・白は異常?天神マイケアクリニック。
おりものの異常 黄緑・茶色・黄色・白 池袋マイケアヒルズタワークリニック。
クラミジアについて - 原因・症状・検査・治療・予防 - 性感染症内科ペアライフクリニック。
性病の種類は?症状・原因・性病検査について詳しく紹介GME医学検査研究所。
おりものの異常 黄緑・茶色・黄色・白 池袋マイケアヒルズタワークリニック。
おりものが黄色・茶色・黄緑・白は異常?天神マイケアクリニック。
クラミジアとHIVの違いって何?性病専門のあおぞらクリニック新橋院。
私のおりものの色やにおいって大丈夫?こんなおりものには要注意!女性ホルモン大学。
おりものの異常について札幌大通駅徒歩3分の婦人科「エナ大通クリニック」。
おりものが黄色・茶色・黄緑・白は異常?天神マイケアクリニック。
おりものが黄色かったり臭い時には性病のリスクがある? – プライベートクリニック高田馬場 – 東京都新宿区。
おりものの異常 - 性病の症状 - 横浜・渋谷・名古屋・札幌・大阪梅田の性感染症内科ペアライフクリニック。
いつもと違う『白色』『透明』のおりもの 病気の可能性は?婦人科・女性のためのクリニック 東京都渋谷区。
性感染症ってなあに? 予防するには?一般社団法人 日本思春期学会。
妊娠初期のおりものの変化生理前や性感染症との違いを解説 産科女性医師監修レディースクリニックなみなみ 東京都目黒区。
おりものが多いかも 」と感じたら要注意⁉疑うべき4つの性病大宮駅徒歩4分 性病検査・治療なら ノワール大宮クリニック。
おりものがズボンまで染みる 黄緑色や血が混じるとき・においが生臭いとき 公式 大阪にある心斎橋駅前婦人科クリニック。
おりものの量・色・ニオイ、これって正常? 医師監修- ワタファク。
おりものの異常 黄緑・茶色・黄色・白 池袋マイケアヒルズタワークリニック。
おりものが黄緑色になるのはなぜ?考えられる病気について徹底解説!wakanote。
クラミジアについて - 原因・症状・検査・治療・予防 - 性感染症内科ペアライフクリニック。
医師監修 クラミジア感染症と不妊の関係 放置は危険!SuguCare スグケア。
おりものが多いかも 」と感じたら要注意⁉疑うべき4つの性病大宮駅徒歩4分 性病検査・治療なら ノワール大宮クリニック。
黄緑おりもの・膿はトリコモナス症?原因と対処法を解説GME医学検査研究所。
おりものの異常 量が増える・黄緑色・悪臭 名古屋栄胃と大腸・消化器内視鏡・性病検査クリニック。
おりものの異常の原因とは?クラミジア感染症など関連する病気大宮駅徒歩4分 性病検査・治療なら ノワール大宮クリニック。
おりものの異常の原因とは?クラミジア感染症など関連する病気大宮駅徒歩4分 性病検査・治療なら ノワール大宮クリニック。
病気が原因の「異常なおりもの」とは? 見極め方を教えて!! 増田美加のドクタートーク Vol.20yoi ヨイ-心・体・性のウェルネスメディア。
おりものの異常 黄緑・茶色・黄色・白 池袋マイケアヒルズタワークリニック。
私のおりものの色やにおいって大丈夫?こんなおりものには要注意!女性ホルモン大学。
楽天市場 女性用 性病検査キット リッチ 8項目 淋菌・クラミジア・カンジダ・トリコモナス・喉淋菌・喉クラミジア・血液梅毒・血液HIV膣検査咽頭検査 血液検査 証明書発行 性感染症 性病 手軽 手早い 簡単 分かりやすい : HARKS。
おりものの量や色、においが変化!?これって病気?おりものの状態から症状をセルフチェック!ネオクリニック。
私のおりものの色やにおいって大丈夫?こんなおりものには要注意!女性ホルモン大学。
おりものが黄色・茶色・黄緑・白は異常?天神マイケアクリニック。
おりもの異常 色・臭い・量渋谷文化村通りレディスクリニック。
おりものの量や色、においが変化!?これって病気?おりものの状態から症状をセルフチェック!ネオクリニック。
おりもの」でわかる体の変化。量、色、におい 危険なサインと予防法とは?医師が徹底解説! - オンライン診療ならウチカラクリニック。